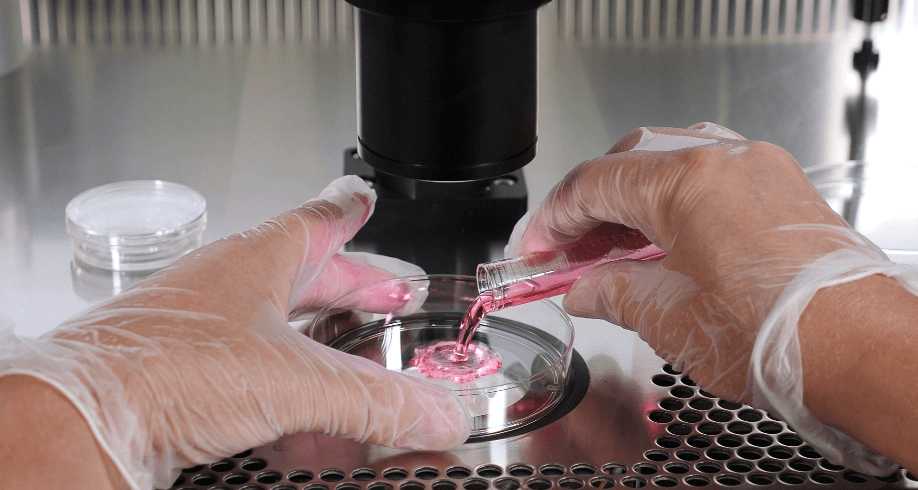
img

About In-Vitro Fertilization (IVF) Treatment
In Vitro Fertilization or IVF is a type of Assisted Reproductive Technology (ART). It uses a combination of medicines and surgical procedures that allows the sperm to fertilize an egg outside the body in a laboratory. This fertilized egg is called an embryo, which is transferred into a woman’s uterus
Ovaries undergo controlled ovarian stimulation, so that multiple follicles are grown in one cycle . Which are then retrieved from the ovaries and fertilised. They are placed in a culture dish and the sperms are allowed to fertilise the eggs by themselves.

IVF ( IN-VITRO FERTILIZATION )
IVF is the most effective form of assisted reproductive technology.
The procedure can be done using a couple's own eggs and sperm.
Process
IVF involves several steps like ovarian stimulation, egg retrieval, sperm retrieval, fertilization and embryo transfer. One cycle of IVF can take about two to three weeks. More than one cycle may be needed.
Procedure
Before starting a cycle of IVF using your own eggs and sperm, you and your partner will likely need various screenings.
Ovulation stimulation
During the stimulation phase of an IVF cycle, patients are administered daily hormone injections to develop the ovarian follicles. It will take around 10 days for ovarian stimulation. During this time our specialists will perform several ultrasound scans and blood tests to track the follicular development.


ICSI ( INTRACYTOPLASMIC SPERM INJECTION )
In this procedure, sperm is directly injected into the egg for fertilization. Then the fertilized egg is placed into your uterus.
Depending on the underlying cause of infertility and your health, your doctor will plan the treatment procedures. It is essential to discuss with your doctor to understand the IVF treatment procedures.

IMSI ( INTRACYTOPLASMIC SPERM INJECTION )
Intracytoplasmic morphologically selected sperm injection (IMSI) is a technique used in IVF treatment to examine and select sperm using a high-magnification digital imaging microscope for microinjection into the egg.
Fertilizing
Retrieved eggs are fertilized either by placing the eggs and sperms in a culture-containing dish (IVF) or by intracytoplasmic sperm injection (ICSI). The eggs are regularly monitored by our embryologists to confirm fertilization.
Egg Retrival
The female partner will be put under mild sedation and the eggs are collected by our specialists. They will then be examined for number, maturity and quality.

After Transfer
Two weeks later, the male partner will be asked to produce a semen sample. The specimen is washed thoroughly, and the optimal sperms are selected. Such sperms can be used for fertilizing the egg or frozen for future use.Two weeks after the embryo transfer, our nursing team will perform a blood pregnancy test on the female partner that measures the pregnancy hormone (b- HCG). The result will be available within 4 hours.

Sperm Retrival
The male partner is asked to produce a semen sample. The specimen is washed thoroughly, and the optimal sperms are selected. Such sperms can be used for fertilizing the egg or frozen for future use.

Book an appointment
You’re welcome to contact our friendly staff who will be happy to assist you and with any general and medical query. Our doctors will recieve or return any urgent calls.
Take the bold step
and achieve your parenthood dream!
It’s never too late to achieve your dream and the dream to become a parent is possible with us. We have seen couples walk into our clinic feeling helpless and worried if they would ever become parents and after undergoing various consultations and treatment plans, they walked out with a third member feeling happy and content.
No matter your age or gender, we are here for you! This clinic is for everyone who wants to be a parent!


